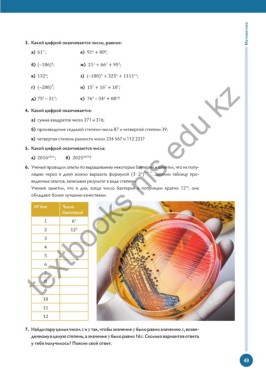

Page 49 -
P. 49
Математика
3. Какой цифрой оканчивается число, равное:
а) 61 ; е) 91 + 80 ;
7
6
8
б) (– 186) ; ж) 21 + 66 + 95 ;
9
7
5
2
в) 132 ; з) (– 180) + 325 + 1111 ;
11
6
5
5
textbooks nis edu kz
г) (– 288) ; и) 15 + 16 + 18 ;
4
7
7
7
д) 75 – 31 ; к) 76 – 34 + 88 ?
2
3
3
2
5
4. Какой цифрой оканчивается:
а) сумма квадратов чисел 271 и 316;
б) произведение седьмой степени числа 87 и четвертой степени 39;
в) четвертая степень разности чисел 234 567 и 112 233?
5. Какой цифрой оканчиваются числа:
а) 2016 2016 ; б) 2025 2025 ?
6. Ученый проводил опыты по выращиванию некоторых бактерий и заметил, что их попу
+ 1
ляцию через n дней можно выразить формулой (3 ∙ 2 ) . Заполни таблицу про
веденных опытов, записывая результат в виде степени.
Ученый заметил, что в дни, когда число бактерий в популяции кратно 12 , они
10
обладают более лучшими качествами.
№ дня Число
бактерий
1 6 2
2 12 3
3
4
5
6
7
8
9
10
11
12
7. Найди пару целых чисел и так, чтобы значение было равно значению , воз ве
денному в целую степень, а значение было равно 16 . Сколько вариантов ответа
у тебя получилось? Поясни свой ответ.
49